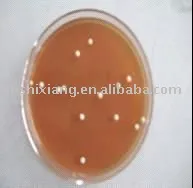
Lactobacillus for animal feed

Wantwant Lactobacillus Beverages
Brand Introduction
The Advantages Of Wantwant Lactobacillus Beverages:
Want Want Holdings Limited, commonly known as Want Want, is a prominent Taiwanese multinational food and beverage company. Founded in 1962 by Tsai Eng-meng, the company initially started as a small rice cracker manufacturer. Over the decades, Want Want has grown into one of the largest and most recognizable snack food companies in Asia.
The brand is best known for its flagship product, Want Want Rice Crackers, which have become a household name across many countries. In addition to rice crackers, the company produces a wide range of products, including dairy beverages, candies, and other snack foods. Want Want has also expanded its portfolio to include media and publishing, owning several television channels and print media outlets in Taiwan and China.
Want Want's success can be attributed to its commitment to quality, innovation, and understanding of consumer preferences. The company has established a strong presence in Mainland China, where it has become one of the leading snack food brands. Its iconic mascot, a cheerful boy with a bowl of rice crackers, has become a symbol of the brand's friendly and approachable image.
With a focus on continuous growth and diversification, Want Want continues to expand its product lines and market reach, maintaining its position as a dominant player in the food and beverage industry across Asia and beyond.
WantWant's brand culture is centered around the core values of happiness, health, and prosperity. The brand aims to bring joy and positivity to people's lives through its diverse range of products, which include snacks, beverages, and other consumer goods. WantWant emphasizes quality and innovation, ensuring that its offerings are not only delicious but also nutritious. The brand is deeply rooted in traditional Chinese culture, often incorporating festive and auspicious elements into its marketing and product designs. WantWant also places a strong emphasis on corporate social responsibility, actively participating in community development and environmental sustainability initiatives. Overall, WantWant strives to create a harmonious and joyful experience for its consumers, making it a beloved household name.
WantWant is a globally recognized brand known for its extensive range of snack products, particularly its iconic rice crackers and flavored milk. Established in Taiwan in 1962, WantWant has grown into a leading food and beverage company with a strong presence across Asia and beyond. The brand is synonymous with quality, innovation, and a commitment to satisfying consumer tastes. Its distinctive logo and memorable advertising campaigns have made WantWant a household name, fostering trust and loyalty among customers. The company’s ability to adapt to diverse markets while maintaining its core values has solidified its position as a major player in the global snack industry. WantWant’s influence extends beyond its products, as it actively engages in corporate social responsibility initiatives, further enhancing its reputation and impact.
Kilogram
Min.order : 1 Kilogram
$50.0000
- $
80.0000
Kilogram
Kilogram
Min.order : 20 Kilogram
$42
- $
50
Kilogram
Min.order : 1 Kilogram
Kilogram
Min.order : 1 Kilogram
$82
- $
99
Kilogram
Min.order : 1 Kilogram
$10
- $
69
Kilogram
Min.order : 1 Kilogram
$2
- $
50
Kilogram
Min.order : 1 Kilogram
$30.0000
- $
30.0000
Kilogram
Min.order : 1 Kilogram
$25
- $
40
Kilogram
Min.order : 2 Kilogram
Kilogram
Min.order : 1 Kilogram
$83
- $
100
Kilogram
Min.order : 1 Kilogram
$4.0000
- $
5.0000
box
$0.1500
- $
0.2000
piece
Min.order : 1 piece
Related Brand:
Raw Pressery Probiotic Drinks
, Actimel
, GoodBelly
, ProViva
, Biotta
, Chobani Probiotic Drinks
, Kombucha
, KeVita
, Müller Vitality
, Culturelle Probiotic Drinks
Related Industry:
Goat milk
, Camel milk powder
, yogurt
, High calcium milk
, milk
, Pure milk
, Buffalo Milk
, Cheese
, Double skin milk
, Skimmed milk
, condensed milk
, Skimmed milk powder
, Whole milk
, Fresh milk
, Student milk
, Milk powder for middle-aged and elderly people
, Empty milk
, Women's milk powder
, Milk beer
, Milk drinks
, coffee
, Coffee drinks
, Coffee beans
, Black coffee
, Capsule coffee
, Ear-hanging coffee
, Cocoa powder
, Soy milk powder
, Soy milk
, Beanflower
, Oat milk
, oatmeal
, Pueraria root powder
, lotus root starch
, Almond powder
, Walnut powder
, Sesame paste
, Coconut powder
, Cereal breakfast
, Plant protein drinks
, Corn juice
, Wheat germ
, Sour plum powder
, Ice cream powder
, Ice powder
, Coconut juice
, Coconut water
, Coconut milk
, Coconut milk
, Grape juice
, Apple juice
, juice
, Green juice
, Apple cider vinegar
, Sugar-free drinks
, Cola
, Sports drinks
, drinks
, Functional beverages
, Carbonated beverages
, Electrolyte beverages
, Solid drinks
, Bubble water
, Soda water
, salt soda water
, Bottle water
, Pure water
, drinking water
, Chia Seeds
, Vegetable Cream
Recommended Related Videos

Please Send Message
${inquiryTitle}